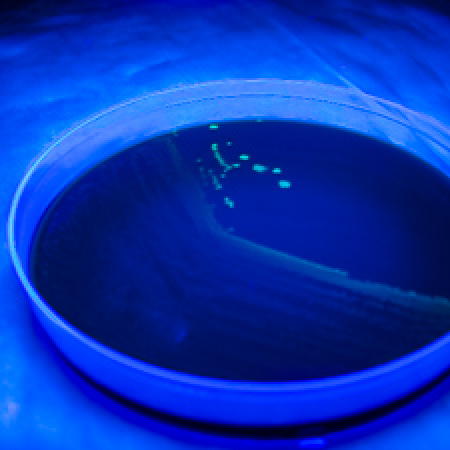
Bacteriology Laboratory Bacteriology Laboratory

The Wadsworth Center Bacteriology Laboratory serves as the New York State public health reference laboratory for bacterial identification and research. The laboratory is responsible for the identification of bacterial pathogens of public health significance as well as collaboration with New York State and New York City epidemiologists across multiple areas. The laboratory is involved in a wide range of testing, surveillance, and applied research activities.
The mission of the laboratory includes continued efforts in applied research to investigate the latest technological advances as well as to maintain testing capabilities necessary for identifying and characterizing emerging infectious diseases and responding to outbreaks and investigations. The unique public health services offered include numerous molecular-based methods that are developed in-house and are important for rapid bacterial identification and characterization. Laboratory services include:
Bacterial Reference
Bacterial isolates submitted from New York State patients are identified and characterized with a variety of culture-based and molecular-based methods. This testing also includes direct clinical specimen testing when culture is not optimal including for unknown bacterial causes, sexually transmitted diseases, Leptospira sp., Streptobacillus moniliformis, as well as for causes of bacterial meningitis often in collaboration with epidemiologists in New York State and New York City.
Surveillance
The Bacteriology Laboratory collaborates with NYS Division of Epidemiology’s Bureau of Immunization and participates as one of ten state health departments contributing national active surveillance data as part of the Emerging Infections Program (EIP). The EIP network is a national resource for surveillance, prevention, and the control of emerging infectious diseases.
Foodborne Bacterial Disease
The Bacteriology Laboratory works closely with the NYS Bureau of Communicable Disease Control (BCDC) as well as the Bureau of Community Environmental Health and Food Protection on outbreak investigations involving foodborne bacteria including both community and healthcare associated investigations. The laboratory is the Northeast Area Laboratory for the Center for Disease Control and Prevention’s PulseNet laboratory network and employs a number of methods and testing algorithms including next generation sequencing (NGS) methods to provide whole-genome sequencing (WGS) for foodborne bacteria isolated in New York.
Healthcare-associated Infections
The Bacteriology Laboratory works closely with epidemiologists in New York State and New York City on outbreak investigations involving numerous bacterial pathogens including Group A Streptococcus and methicillin-resistant Staphylococcus aureus (MRSA) utilizing newer NGS approaches and analysis to understand and reduce the spread of healthcare acquired illness.
Antimicrobial Resistance
As the Northeast AR Lab Network regional laboratory, the Bacteriology Laboratory rapidly detects antibiotic resistant bacteria and informs local responses to prevent spread and protect people. This testing closes the gap between local capabilities and the data needed to combat antibiotic resistance by providing comprehensive testing to characterize the antibiotic-resistant bacteria utilizing cutting-edge technology, including NGS to support this nationwide effort.
Legionnaires' Disease and Legionella
The Bacteriology Laboratory works closely with epidemiologists in New York State and New York City as well as the Center for Environmental Health on outbreak investigations involving Legionella implicated in both the community and healthcare facilities. As Legionella bacteria are found naturally in the environment, usually in water and can grow in hot tubs, cooling towers, hot water tanks, large plumbing systems, public health water testing is often combined with clinical testing of patients to determine exposure sources.
Tickborne Bacterial Disease
The Bacteriology Laboratory works in conjunction with the NYS Bureau of Communicable Disease Control (BCDC) to provide bacterial clinical testing and surveillance testing for New York State to detect tickborne bacteria such as Anaplasma phagocytophilum, Ehrlichia chaffeensis, Borrelia burgdorferi , Borrelia miyamotoi, and Bartonella species.
Research
The Bacteriology Laboratory evaluates the performance of available diagnostic test methods and develops and validates new laboratory assays for bacteria. In addition, the Bacteriology Laboratory collaborates with scientists in state public health, clinical and academic laboratories as well as the Centers for Disease Control and Prevention and the Association of Public Health Laboratories on an assortment of research and applied research projects including Public Private Partnerships.
Training/Education
The Bacteriology Laboratory welcomes students from the University at Albany School of Public Health as well as Trainees and Fellows from a variety of Fellowship Programs. Opportunities include short-term rotations and longer-term applied research projects focused on bacterial disease.